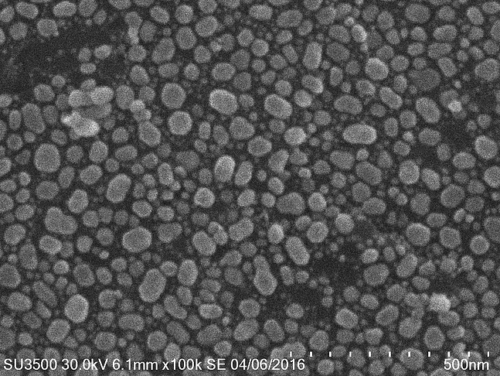

用于SEM-FIB-TEM的VAIS-PB系列主动隔振基座平台


VAIS-PB系列用作电子显微镜的临界抗振基底,专门设计用于为更大,昂贵的Fe-SEM,SEM / FIB和TEM系统提供最高的精度成像。这些有源振动隔离底板(或经常被称为抗振动底座)在其类中具有最佳性能。每个VAIS-PB防振底座专门针对其有效载荷或电子显微镜定制。每个系统都是专业安装和调整,以提供最佳性能,并在将来提供最佳性能。
与标准功能,如自动调平,实时监测-您会发现VAIS-PB抗振动基础是一个无价的配件,将显著提高您的成像分辨率,让您获得最大的能力,为您的显微镜投资。
使显微镜比以往任何时候都更容易:
- manbetx提款为什么速度快e扫描电子显微镜
- 场发射扫描电子显微镜manbetx提款为什么速度快e
- 聚焦离子束显微镜
- 透射电子显微镜
- 扫描透射电子显微镜
- 扫描隧道显微镜(STM)
- 超精密计量和profilectry.
- 等大型地板上安装的振动敏感装置
优越的振动抑制
VAIS-PB在关键的1至10hz范围内通过提供90%的2hz振动隔离和99%的10hz振动隔离在降低振动非常有效,电子显微镜往往是不稳定的,容易受到环境振动。振动抑制持续到100赫兹。
克服被动隔离系统的局限性
被动隔振系统的固有频率通常在1.5至10hz之间,在这种情况下,受迫频率较低的振动与固有频率重合,从而放大而不是减小振动。
我们的VAIS-PB系列通过将系统的固有频率降低到亚赫兹范围来克服这一弱点。因此,VAIS-PB系列在控制1 - 5hz的振动敏感工具往往不稳定和破坏,不能产生最佳结果时,是非常有效的。VAIS-PB系列从0.5 Hz开始降低振动,在2hz时提供80 - 90%的振动。
随着该透射性图所示,主动系统在控制1-10Hz范围内的控制中,其中无源系统放大了低频振动而不是过滤它们。VAIS-PB系统在隔离超精密的显微镜和仪器的高度有效,从这些低频振动中的精密仪器往往是不稳定和中断的。

自定义调优的最大性能
每个VAIS-PB系统在安装过程中都经过专业调试,为其支持的显微镜有效载荷提供最佳性能。在未来的任何时候,都可以通过与系统的临时远程链接轻松地更新调优。
每个安装地点都有不同的振动级别,需要调整VAIS-PB以尽可能地抑制振动。我们的工程师测量振动源,以有效地调整反馈和前馈控制系统,这是控制振动在1-10赫兹范围的关键因素。如果不进行调整,主动隔振基础平台就无法提供最佳的隔振性能。

控制振动在所有6度自由中
安装在主动振动隔离系统中的惯性传感器和致动器检测和控制三个平移的运动(X,Y和Z)的振动,以及三个旋转运动(俯仰,卷和偏航)。

以下部分为VAIS-PB平台可使用的电子显微镜型号:
- SU-9000冷场发射FE-SEM
- SU-8200冷场发射FE-SEM
- 轩辕8220 / 8230 / 8240
- SU-5000场发射FE-SEM